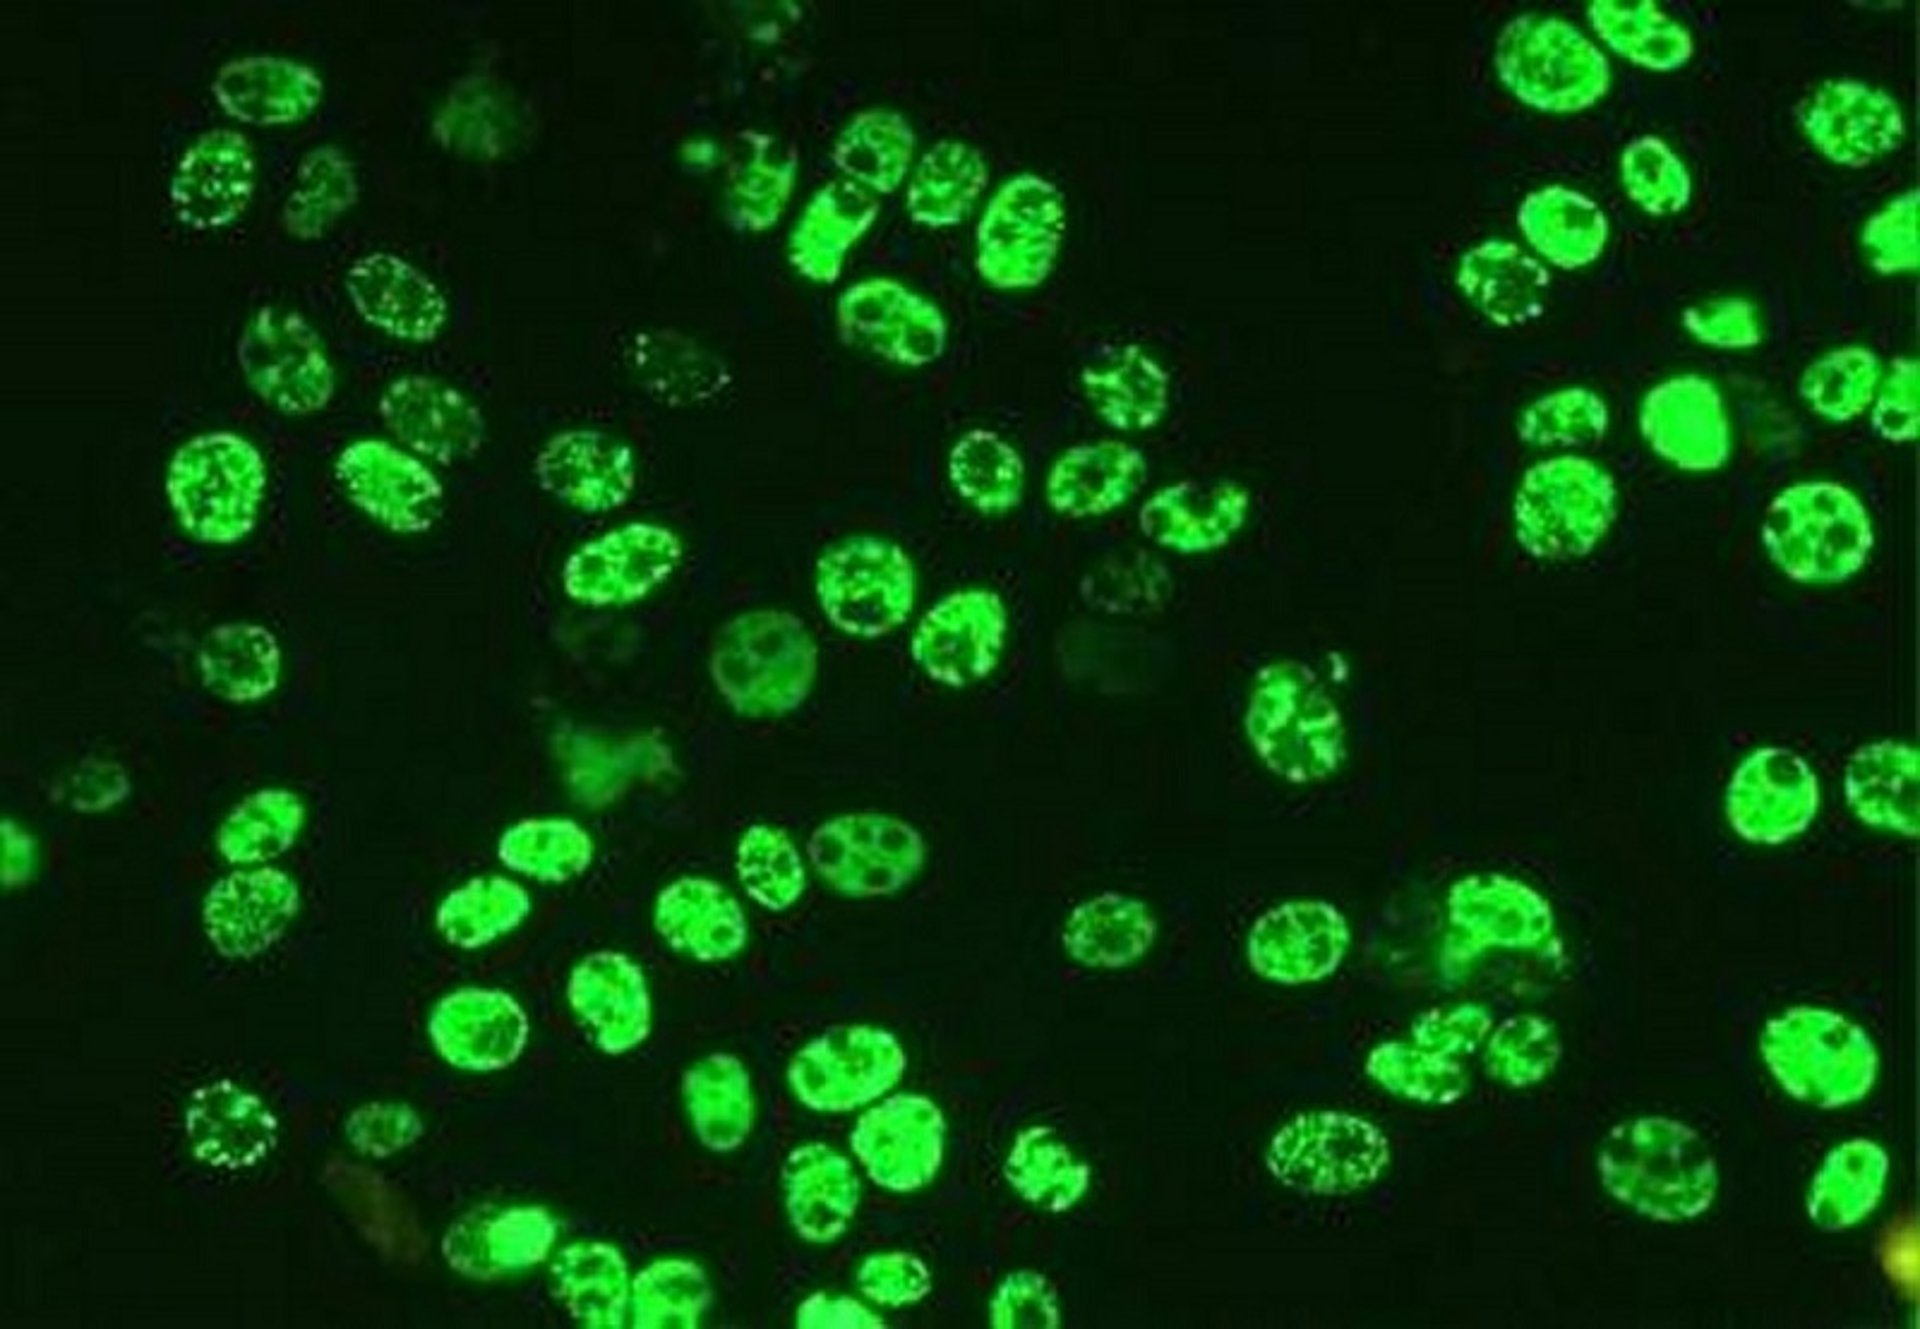
Porcine circovirus 2, immunofluorescence, photomicrograph

Porcine circovirus 2, immunofluorescence, photomicrograph
Photomicrograph showing PK-15 cells infected with porcine circovirus 2 (PCV2) and immunostained using a PCV2-specific monoclonal antibody conjugated with fluorescein isothiocyanate (FITC).
Courtesy of Dr. Gordon Allan.
In these topics